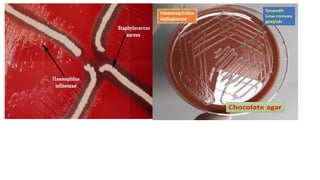

Haemophilus is a genus of Gram-negative, nonmotile bacteria that are typically small coccobacilli in shape. They require factors like hemin and NAD found in blood or chocolate agar to grow. While most Haemophilus species live harmlessly in their hosts, some like H. influenzae and H. ducreyi can cause disease. H. influenzae commonly causes infections like pneumonia, meningitis, and epiglottitis in young children, but routine use of the Hib vaccine in many countries has significantly reduced cases of invasive Hib disease. Unencapsulated H. influenzae strains still cause ear, eye, and sinus infections in children.